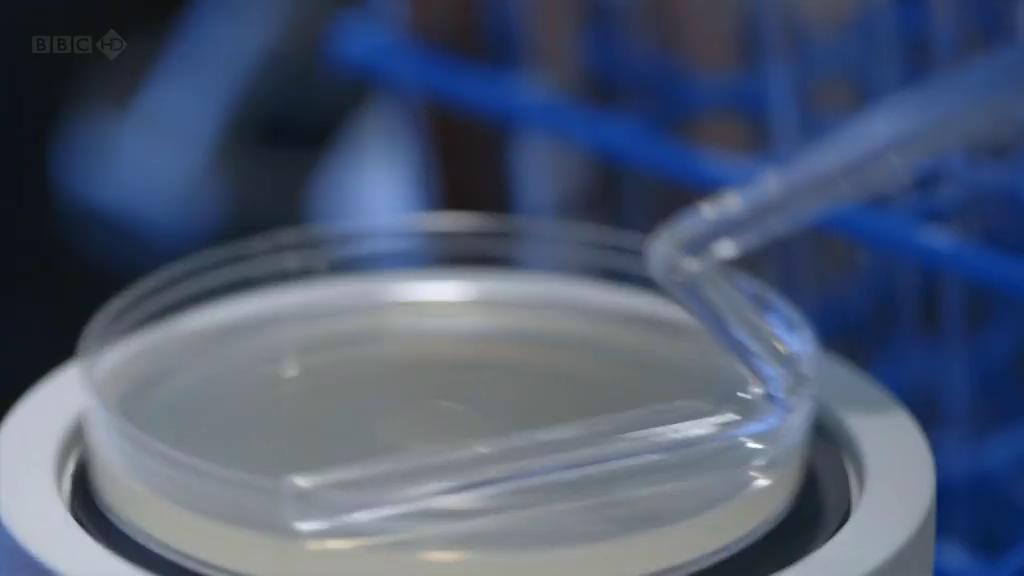
地平线系列：战胜超级病菌 Horizon: Defeating the Superbug

在世界各地,我们已经看到流氓细菌的出现。 这些都是超级病菌,危险的细菌正在抵抗我们唯一的防御:抗生素。 在世界各地跟踪这些潜在杀手蔓延的科学家,研究人员正在开发击败这些超级细菌的新技术。
















在世界各地,我们已经看到流氓细菌的出现。 这些都是超级病菌,危险的细菌正在抵抗我们唯一的防御:抗生素。 在世界各地跟踪这些潜在杀手蔓延的科学家,研究人员正在开发击败这些超级细菌的新技术。

当前链接:https://ziyuan.yunduozy.com/112485.html
文章标题:地平线系列:战胜超级病菌 Horizon: Defeating the Superbug
文章版权:云朵资源网 (https://ziyuan.yunduozy.com) 所发布的内容,部分为原创文章,转载请注明来源,网络转载文章如有侵权请联系我们!
本文最后更新发布于:2026年01月27日 12:35,某些文章具有时效性,若有错误或已失效,请在下方留言。